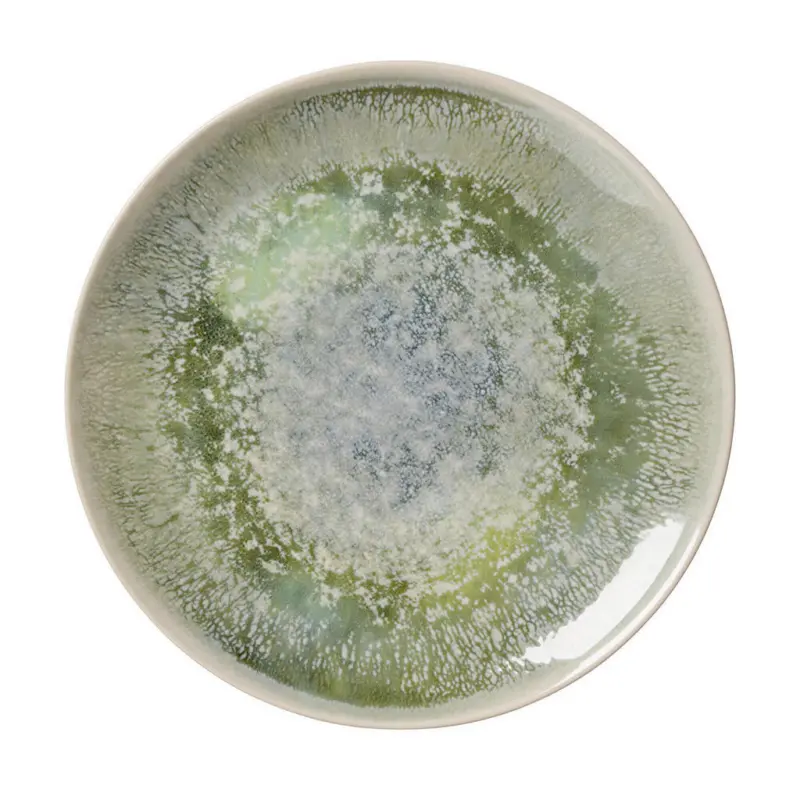
Speiseteller Cecina Jade

Speiseteller Cecina Jade bei XXXLutz Lauterach - Ihr Möbelhaus bei Bregenz
- Preis nur
- 9,99 €

Aktuelles XXXLutz Flugblatt
Flugblatt gültig bis: 14.04.2026
Wo gibt's Speiseteller Cecina Jade?
Verfügbarkeit und Preisentwicklung
Speiseteller Cecina Jade ist derzeit in ausgewählten XXXLutz Filialen in Österreich zum Preis von 9,99 € erhältlich. Die XXXLutz Filiale Karl-Höll-Straße 11, 6923 Lauterach ist 9,96 km entfernt und hat heute von 09:00 bis 19:00 Uhr geöffnet.